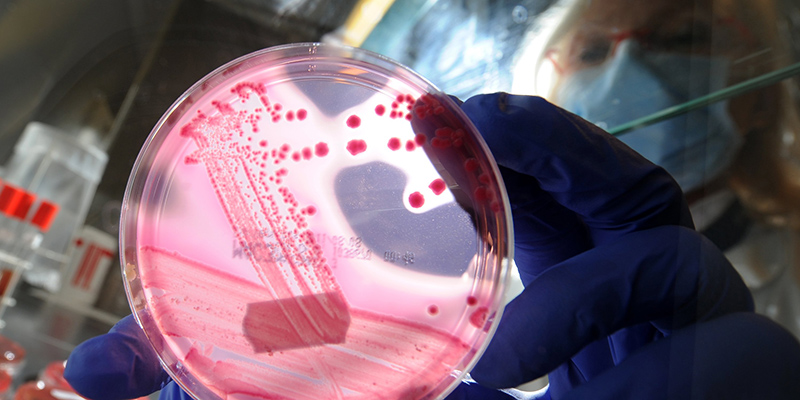

Non è l’apocalisse degli antibiotici
La scoperta di un batterio "resistente agli antibiotici" di questi giorni era attesa ed è preoccupante, ma meno di come è stata raccontata
Negli ultimi giorni si è parlato molto del caso di un batterio resistente agli antibiotici identificato per la prima volta negli Stati Uniti, su una paziente di 49 anni della Pennsylvania. Molti giornali hanno raccontato la notizia con toni allarmati e titoli come “Scoperto il batterio che resiste a tutti gli antibiotici”, “Il super batterio più forte degli antibiotici” e “Terrore per il super-batterio più forte di ogni antibiotico”, mentre domenica sera su RaiTre al tema ha accennato anche la trasmissione Report nell’ambito di un’inchiesta più ampia sugli antibiotici. La scoperta negli Stati Uniti non è da sottovalutare e solleva qualche preoccupazione, ma non nei termini sensazionalistici con cui è stata raccontata a volte negli ultimi giorni.
Infezione da E. coli
Sulla rivista scientifica Antimicrobial Agents and Chemotherapy un gruppo di ricercatori del Walter Reed National Military Medical Center (Maryland) ha scritto di avere identificato con certezza per la prima volta negli Stati Uniti un’infezione da batterio Escherichia coli (E. coli) in una paziente, resistente alle tradizionali terapie antibiotiche per fermarlo. La somministrazione della colistina, un antibiotico di ultima scelta quando gli altri falliscono, non ha portato a benefici e ha reso necessaria la somministrazione di altri farmaci e combinazioni di antibiotici per curare la paziente, che è poi riuscita a superare l’infezione.
Escherichia coli fa parte del gruppo degli enterobatteri: vive nelle parte inferiore del nostro intestino e di quello di migliaia di altre specie animali a sangue caldo. Grazie alla sua attività riusciamo a digerire meglio il cibo che ingeriamo e assimilarlo. È quindi una risorsa molto importante per la nostra sopravvivenza e per quella degli altri animali. A volte però il batterio muta, dando vita a nuove varianti aggressive che il nostro organismo non riesce a tenere sotto controllo. Il batterio si riproduce molto rapidamente nell’intestino e può causare infezioni anche gravi in chi lo ospita. Le varianti solitamente più pericolose appartengono ai ceppi EHEC e sono presenti principalmente nel bestiame. A noi arrivano attraverso l’ingestione di cibi contaminati come carne poco cotta, latte non pastorizzato o frutta e verdura concimate con letame infetto e consumate senza un accurato lavaggio. Non è ancora noto come la paziente della Pennsylvania abbia contratto il batterio.
Cosa c’è di preoccupante
Notando la resistenza di E. coli ai trattamenti tradizionali, i ricercatori hanno analizzato alcuni campioni del batterio della loro paziente, scoprendo che la resistenza alla colistina era data dalla presenza del gene mcr-1 in un “plasmide”, un filamento di DNA circolare che si può spostare tra le cellule trasmettendo le sue informazioni genetiche. Mcr-1 era noto ai ricercatori: fu identificato per la prima volta in un campione di E. coli trovato in un maiale in Cina un anno fa, e successivamente in alcuni pazienti in Malesia ed Europa.
Già nel 2015 la scoperta fu definita “preoccupante” da ricercatori ed esperti, perché la diffusione del gene è resa molto più semplice e rapida dalla sua presenza nel plasmide, che può essere scambiato tra le cellule batteriche attraverso un processo di trasferimento genico orizzontale: il materiale genetico viene trasmesso a una cellula non discendente, a differenza del trasferimento verticale con il quale la trasmissione avviene attraverso la riproduzione. Semplificando, un batterio con mcr-1 è resistente alla colistina e, trasmettendo l’informazione genetica attraverso un plasmide, può insegnare agli altri batteri lo stesso trucco per diventare resistenti all’antibiotico. La preoccupazione dei ricercatori riguarda il fatto che questa condivisione di informazioni può avvenire anche tra batteri di diverso tipo, compresi quelli già noti per essere resistenti a un ampio spettro di antibiotici.
È davvero resistente a tutti gli antibiotici?
No. La mutazione ha reso E. coli nella paziente della Pennsylvania resistente ai classici antibiotici somministrati per contrastarlo e alla colistina, ma non a tutti gli antibiotici conosciuti e utilizzati in medicina. Quando si parla di “antibiotico di ultima scelta”, di solito si fa riferimento a farmaci molto potenti che vengono dati al paziente dopo avere provato tecniche meno invasive, nel caso in cui gli altri non abbiano funzionato. Vengono definiti così perché possono causare seri effetti collaterali e devono essere somministrati sotto attenta osservazione del medico. La colistina, per esempio, è un vecchio antibiotico molto potente che può causare danni gravi ai reni. Di solito il suo utilizzo permette di curare le infezioni più gravi da E. coli, ma nel caso della paziente della Pennsylvania non ha funzionato e si è reso necessario l’utilizzo di altri antibiotici di ultima scelta, che combinati insieme hanno permesso di tenere sotto controllo l’infezione.
Carbapenemi e CRE
In alcuni articoli pubblicati la settimana scorsa, su diversi siti internazionali di news, si parlava erroneamente di una resistenza del batterio ai carbapenemi, una classe di antibiotici ad ampio spettro che viene somministrata solo in ambito ospedaliero. I batteri che non rispondono ai trattamenti con questi farmaci sono definiti CRE (carbapenem resistant enterobacteriaceae) e sono tra le principali preoccupazioni delle organizzazioni sanitarie, perché iniziano a essere numerosi e in media solo un paziente su due sopravvive a infezioni batteriche di questo tipo. Il batterio di cui si parla in questi giorni non è comunque un CRE: è resistente a numerosi antibiotici ma non ai carbapenemi. Se però la mutazione identificata lo scorso anno si trasmettesse a qualche batterio CRE, potrebbero esserci problemi più seri.
Quindi?
La scoperta sulla paziente della Pennsylvania non deve essere sottovalutata, ma nemmeno ingigantita: mcr-1 era già noto ai ricercatori e ci si aspettava che prima o poi venisse individuato anche negli Stati Uniti, dopo le scoperte dell’ultimo anno in Asia ed Europa. Non sappiamo da quanto tempo esista la mutazione, né si può affermare con certezza che cosa l’abbia causata. L’eccessivo consumo di antibiotici da parte della popolazione è uno dei principali indiziati, perché può rendere più probabile la selezione di batteri con mutazioni che li rendono resistenti ai farmaci. Non è comunque ancora chiaro se e come mcr-1 contribuirà eventualmente a rendere più frequenti le infezioni batteriche resistenti agli antibiotici.



